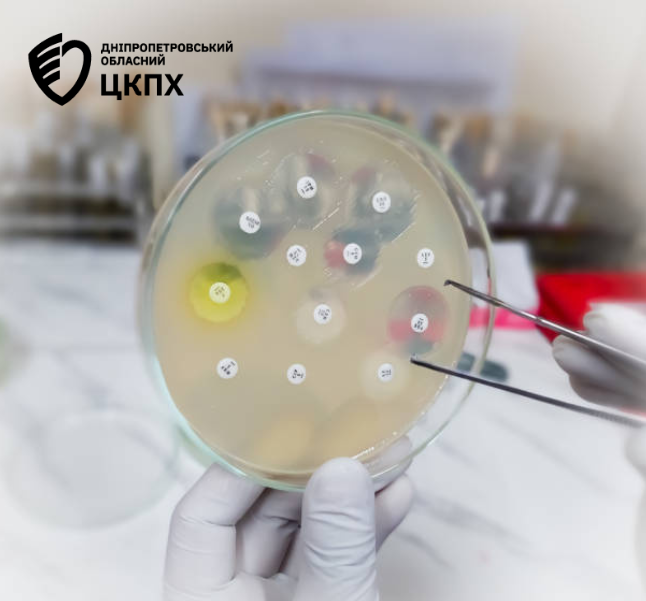

Антибіотикорезистентність: глобальна загроза, що вже поряд
14 травня 2025
У рамках Європейського тижня громадського здоров’я ми хочемо привернути увагу до серйозної, але часто недооціненої загрози — антибіотикорезистентності (АР).
Це явище, при якому бактерії стають стійкими до антибіотиків, роблячи звичні методи лікування неефективними.
Що таке антибіотикорезистентність?
Антибіотикорезистентність (АР) — це здатність бактерій протистояти дії антибіотиків. Це не означає, що організм людини звикає до ліків — навпаки, це бактерії змінюються, і препарати, які раніше їх знищували, більше не працюють.
Чому це важливо?
За даними ВООЗ, АР щороку забирає понад 1,2 мільйона життів у світі. Проблема стрімко загострюється і в Україні.
Актуальні дані для України:
- 50% E. coli — резистентна до ампіциліну та цефалоспоринів ІІІ покоління
- 30% Staphylococcus aureus — метицилін-резистентні (MRSA)
- 40% Klebsiella pneumoniae — не піддаються лікуванню карбапенемами
- Щороку фіксується понад 10 000 важких інфекцій, які важко піддаються лікуванню
Причини поширення резистентності:
🔹 Безконтрольне або неправильне використання антибіотиків (без призначення лікаря, “на всяк випадок”, при ГРВІ)
🔹 Незавершене лікування — коли пацієнт припиняє прийом ліків після перших покращень
🔹 Вживання антибіотиків у тваринництві для стимуляції росту або профілактики
🔹 Погана інформованість населення
🔹 Недотримання інфекційного контролю в медичних закладах
Міжнародна співпраця
Україна є активним учасником глобального епіднагляду за антимікробною резистентністю (GLASS, ВООЗ) і стратегічним партнером у програмах біомедичної безпеки.
Полковник Джейсон Беннетт, Армійський дослідницький інститут імені Волтера Ріда (WRAIR):
“Антимікробна резистентність є однією з найсерйозніших глобальних загроз для здоров’я. Україна відіграє ключову роль у регіональному та міжнародному епіднагляді. Ми високо цінуємо зусилля українських партнерів у впровадженні систем моніторингу, вдосконаленні лабораторної діагностики та обміні критичними даними. Разом ми маємо шанс зупинити поширення супербактерій.”
Що може зробити кожен?
Не приймати антибіотики без призначення лікаря
Завжди завершувати призначений курс лікування
Не ділитися антибіотиками з іншими
Дотримуватись особистої гігієни
Вакцинуватись, щоб зменшити ризик інфекцій
️ Захисти себе — захисти майбутнє
Кожен з нас має силу зупинити поширення антибіотикорезистентності.
Відповідальність за використання антибіотиків — це внесок у безпечне завтра.
Діліться цією інформацією — допоможіть сформувати свідоме суспільство.
Разом ми сильніші перед глобальними загрозами.
#Антибіотикорезистентність #ЄвропейськийТижденьЗдоров’я #StopAMR #АнтибіотикиЗРозумом #ГромадськеЗдоров’я #WRAIR #Здоров’яУкраїни



